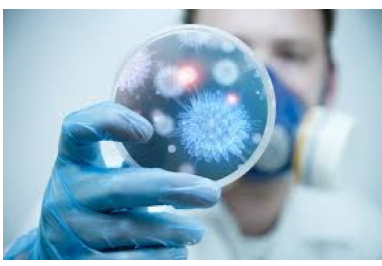
Медики назвали три симптоми раку, які не можна ігнорувати Медики назвали три симптоми раку, які не можна ігнорувати

Медики назвали три симптоми раку, які не можна ігнорувати
Медики назвали три симптоми раку, які не можна ігнорувати
У разі своєчасного виявлення проблеми можна скоротити ризик злоякісних процесів в організмі.
Хірург-онколог назвав три симптоми, які небезпечно ігнорувати. Вони можуть бути провісниками розвитку раку.
Тривожною ознакою фахівець назвав появу печії. У разі наявності цієї проблеми важливо відвідати гастроентеролога. Якщо ліки, призначені лікарем, не дають ефекту, рекомендовано пройти гастроскопію. У разі своєчасного виявлення проблеми можна скоротити ризик злоякісних процесів в організмі.
Небезпечним проявом є і дисфагія. При останній виникає відчуття кома в горлі, все тому, що має місце порушення проходження їжі. Для оцінки стану буде корисним пройти рентгенографію.
Не можна залишати поза увагою раптові і безпричинні кашель і захриплість голосу. Пояснюватись симптом може наявністю рефлюкс-езофагіту, але не виключено, що відбувається здавлювання нервів з вини пухлини. Панікувати через такі прояви не варто, але й ігнорувати їх небезпечно.
Джерело: Новини Ю
Танцювали на автомобілі: поліція притягнула до відповідальності молодиків у Миколаєві (відео)
Через несправний світлофор зіткнулися Kia і Fiat в центрі Миколаєва: постраждала дитина (відео)
8 березня у Миколаєві: на квіткових ринках ажіотаж (фоторепортаж)
Mercedes перевернув Mitsubishi у Миколаєві: двох людей забрала «швидка» (відео)
Вечірня атака на Миколаїв: очевидці повідомили подробиці
Вечірня атака на Миколаїв: «шахед» пробив залізобетонну стіну дев'ятиповерхівки (фото, відео)
Чип iPhone 16 та найнижча ціна: у Apple представили новий MacBook Neo
У Миколаєві пролунав вибух: над містом збили «шахед» (відео)
Вибухи у Миколаєві: над містом шахеди, працює ППО (відео)













